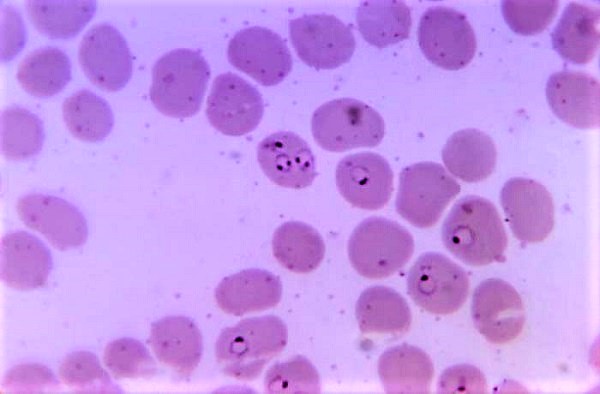

Los SMS que pueden salvar vidas
El País informa del impacto que NUTRI-m, el programa de Fundación Recover que busca reducir la desnutrición infantil en África, ha tenido ya en la vida de 4.000 niños

El País informa del impacto que NUTRI-m, el programa de Fundación Recover que busca reducir la desnutrición infantil en África, ha tenido ya en la vida de 4.000 niños

El programa de RTVE Alianza 2030 repasa con la directora general de Fundación Recover, Marta Marañón, algunos de los hitos más significativos de la fundación

Marta Marañón, directora general de Fundación Recover, explica la importancia del nuevo laboratorio de anatomía patológica de Burundi en un artículo en Corresponsables

La directora de Fundación Recover, Marta Marañón, repasa en esta entrevista con RTVE algunos datos alarmantes de salud en África

África Hoy, programa de RTVE, se hace eco del proyecto que ponen en marcha Fundación Recover y Fundación Kyrikú

Entrevista a Marta Marañón, directora de Fundación Recover, en África Hoy, de RTVE, con motivo del Día Internacional de la Mujer

El programa de RTVE África Hoy entrevista a Marta Marañón en el Día Mundial de las ONG

El diario El Confidencial recoge la importante labor que realiza Fundación Recover en el continente africano

La directora de Fundación Recover ha explicado al diario cuáles son los objetivos de Recover y cómo es la asistencia sanitaria en los países en los que trabajamos.

El diario recoge los tres ejes de actuación principales de la fundación: centros de salud, formación y pacientes

En el trabajo que Fundación Recover realiza para la infancia destaca el proyecto NUTRI-m, lanzado en 2021 y que gracias a varios desarrollos tecnológicos permite conocer el estado nutricional de
Las mosquiteras tratadas con insecticida son una de las principales herramientas contra la malaria, según expertos

«La visita a Albacete de Marta Marañón, Directora General de Fundación Recover, ha supuesto un notable empuje para nuestra actividad en la ciudad manchega»

Marañón explica la misión y la labor de Fundación Recover y comparte algunas pinceladas de su trayectoria y su vida más personal

Os animamos a escuchar la entrevista que África Hoy ha realizado a Marta Marañón, Directora General de Fundación Recover, donde conversaron sobre el reciente viaje por Camerún y el seguimiento de los proyectos
© Copyright 2024 – Fundación Recover Hospitales para África
© 2024 – Fundación Recover Hospitales para África
0,6 Médicos/10.000 Habitantes
Desde 2018
1 centro de salud intervenido
Becas de formación y equipamiento de laboratorio, unidad de nutrición e intervención de pacientes en España
Incidencia en 10.000 personas

1,24 Médicos/10.000 Habitantes
Desde 2007
71 centros de salud intervenidos
Gestión hospitalaria, infraestructuras de electricidad agua y saneamiento, campañas de salud (desnutrición infantil, cáncer de cérvix, riesgo cardiovascular, paludismo, drepanocitosis) equipamiento (de quirófano, laboratorio y fisioterapia, aparatos rayos X, ecógrafos, electrocardiogramas, incubadoras, sillas dentales, ambulancias, etc.), becas de formación en España y en África, Telemedicina, intervención de 63 pacientes en España.
Incidencia en 998.218 personas

0,65 Médicos/10.000 Habitantes
Desde 2024
1 centros de salud intervenido
Laboratorio de anatomía patológica de referencia
Incidencia en 78.031 personas

3,7 Médicos/10.000 Habitantes
Desde 2017
7 centros de salud intervenidos
Formación en España, equipamiento laboratorio, agua potable y Telemedicina
Incidencia en 30.500 personas

1 Médico/10.000 Habitantes
Desde 2007
3 centros de salud intervenidos
Intervención de pacientes cardíacos en España, telemedicina
Incidencia en 60.000 personas

0,62 Médicos/10.000 Habitantes
Desde 2018
2 centros de salud intervenidos
Infraestructura maternidad, agua potable, energía, equipamiento ecografía, gestión
Incidencia en 20.850 personas


Esta web utiliza cookies para que podamos ofrecerte la mejor experiencia de usuario posible. La información de las cookies se almacena en tu navegador y realiza funciones tales como reconocerte cuando vuelves a nuestra web o ayudar a nuestro equipo a comprender qué secciones de la web encuentras más interesantes y útiles.
Las cookies estrictamente necesarias tiene que activarse siempre para que podamos guardar tus preferencias de ajustes de cookies.
Si desactivas esta cookie no podremos guardar tus preferencias. Esto significa que cada vez que visites esta web tendrás que activar o desactivar las cookies de nuevo.
Esta web utiliza Google Analytics para recopilar información anónima tal como el número de visitantes del sitio, o las páginas más populares.
Dejar esta cookie activa nos permite mejorar nuestra web.
¡Por favor, activa primero las cookies estrictamente necesarias para que podamos guardar tus preferencias!